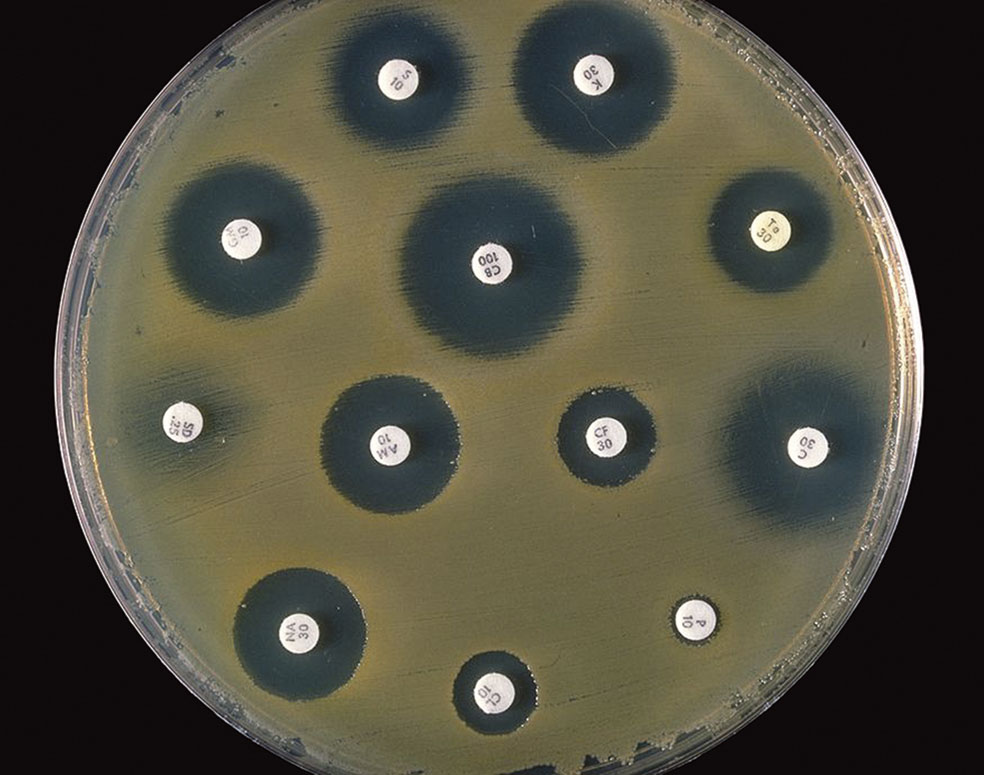
alternative text

Nueva alerta sanitaria ¿De dónde sale esta letal amenaza? Virus de Marburgo: el pariente del ébola, al acecho

Detectado por primera vez en la ciudad alemana que le da nombre, un brote del letal virus de marburgo en Guinea ecuatorial ha desatado la alerta de la OMS. En España, médicos valencianos aislaron hace pocos días a un paciente sospechoso de portar el virus que, por suerte, resultó ser negativo.
Marburgo es célebre por su universidad. Nueve premios Nobel justifican esa fama. En 1967, sin embargo, se detectó un virus desconocido en la ciudad. Hubo 31 contagiados y 7 muertos.
Desde entonces, la plácida y casi milenaria ciudad alemana da nombre a un patógeno, protagonista ahora de la última alarma lanzada por la OMS. Guinea Ecuatorial es el escenario de un nuevo brote en expansión cuya mortalidad ya supera al cincuenta por ciento de los contagiados. La OMS califica la cepa del brote como «altamente infecciosa».
Hablamos, de hecho, de un virus que se contagia con facilidad por contacto directo con infectados o superficies y materiales contaminados.

Otro foco de transmisión es la manipulación de los cadáveres, algo frecuente en el país afectado, donde se realizan ceremonias funerarias en las que los familiares tocan al difunto. Se trata de un microorganismo similar al ébola, tan temido entre los africanos tras la pandemia que en 2014 provocó más de 11.000 muertos en varios países. El mayor brote conocido del Marburgo, por su parte, se produjo en Angola en 2005, cuando mató a 329 personas.
De momento, la región del brote es una zona poco poblada del norte del país, vecina a Camerún –ya ha restringido el paso por su frontera–, y, como medida preventiva, se ha confinado a más de 4000 personas.
En 2005, el virus mató a 329 personas en Angola, su brote más mortal
No existe, además, tratamiento que lo neutralice, aunque una buena rehidratación y la administración rápida de herramientas terapéuticas como antivirales mejoran la supervivencia de los pacientes.
Condiciones estas, en todo caso, difíciles de conseguir en la ubicación del foco actual. Allí han podido comprobar de primera mano de lo que es capaz este patógeno que causa una enfermedad que se desata de forma brusca y produce manifestaciones hemorrágicas graves –a menudo en varios órganos–, sangre en vómitos y heces, fiebre alta, dolor de cabeza y musculares y una afectación del sistema nervioso central que puede generar confusión, irritabilidad y agresividad.
Los pacientes parecen fantasmas: ojos hundidos, inexpresividad, letargo...
Es frecuente también la aparición de diarrea acuosa intensa, dolor y cólicos abdominales, náuseas, vómitos o inflamación de testículos. Los pacientes, según algunas descripciones clínicas, presentan «aspecto de fantasmas» debido al hundimiento de los ojos, la inexpresividad facial y un letargo pronunciado.

Por lo que respecta a su propagación, los expertos consideran improbable que el virus se extienda por Europa, aunque podría llegar si algún contagiado presintomático viajase durante el periodo de incubación, que oscila entre los 2 y los 21 días.
En España, hace unos días saltaron las alertas en el Hospital Universitario y Politécnico La Fe de Valencia, al detectarse a un paciente de 34 años que presentaba síntomas compatibles con la infección que produce el virus. Tras pasar un día en la Unidad de Aislamiento de Alto Nivel y no detectarse rastro del patógeno fue dado de alta.
Otras amenazas que llaman a la puerta

Bacterias prehistóricas bajo el Permafrost
El deshielo ártico ya está liberando bacterias y virus con miles de años de antigüedad resistentes a los métodos terapéuticos conocidos. Se han detectado ya más de 100 microorganismos con este perfil. La desaparición del permafrost, que cubre 23 millones de kilómetros cuadrados en el hemisferio norte, libera a la atmósfera, además, gases de efecto invernadero, como dióxido de carbono y metano.
Multirresistencias
El abuso en la administración de antibióticos –en personas y animales– genera cada vez más bacterias resistentes a esta capital herramienta terapéutica. Estas superbacterias, de hecho, ya matan a 1,3 millones de personas cada año. Las proyecciones previas a la pandemia hablaban de 10 millones en 2050. Dado que la covid disparó el uso de antibióticos, las cifras bien podrían ser mayores.

-
1 El superpoder de los sueños lúcidos (y el negocio de dominar el inconsciente)
-
2 El principito, camino del trono: así es el heredero de Mónaco
-
3 La vida empieza así: viaje al misterio de la gestación
-
4 «La inteligencia artificial se sentará en el Consejo de Ministros»
-
5 El asombroso universo bajo nuestros pies









